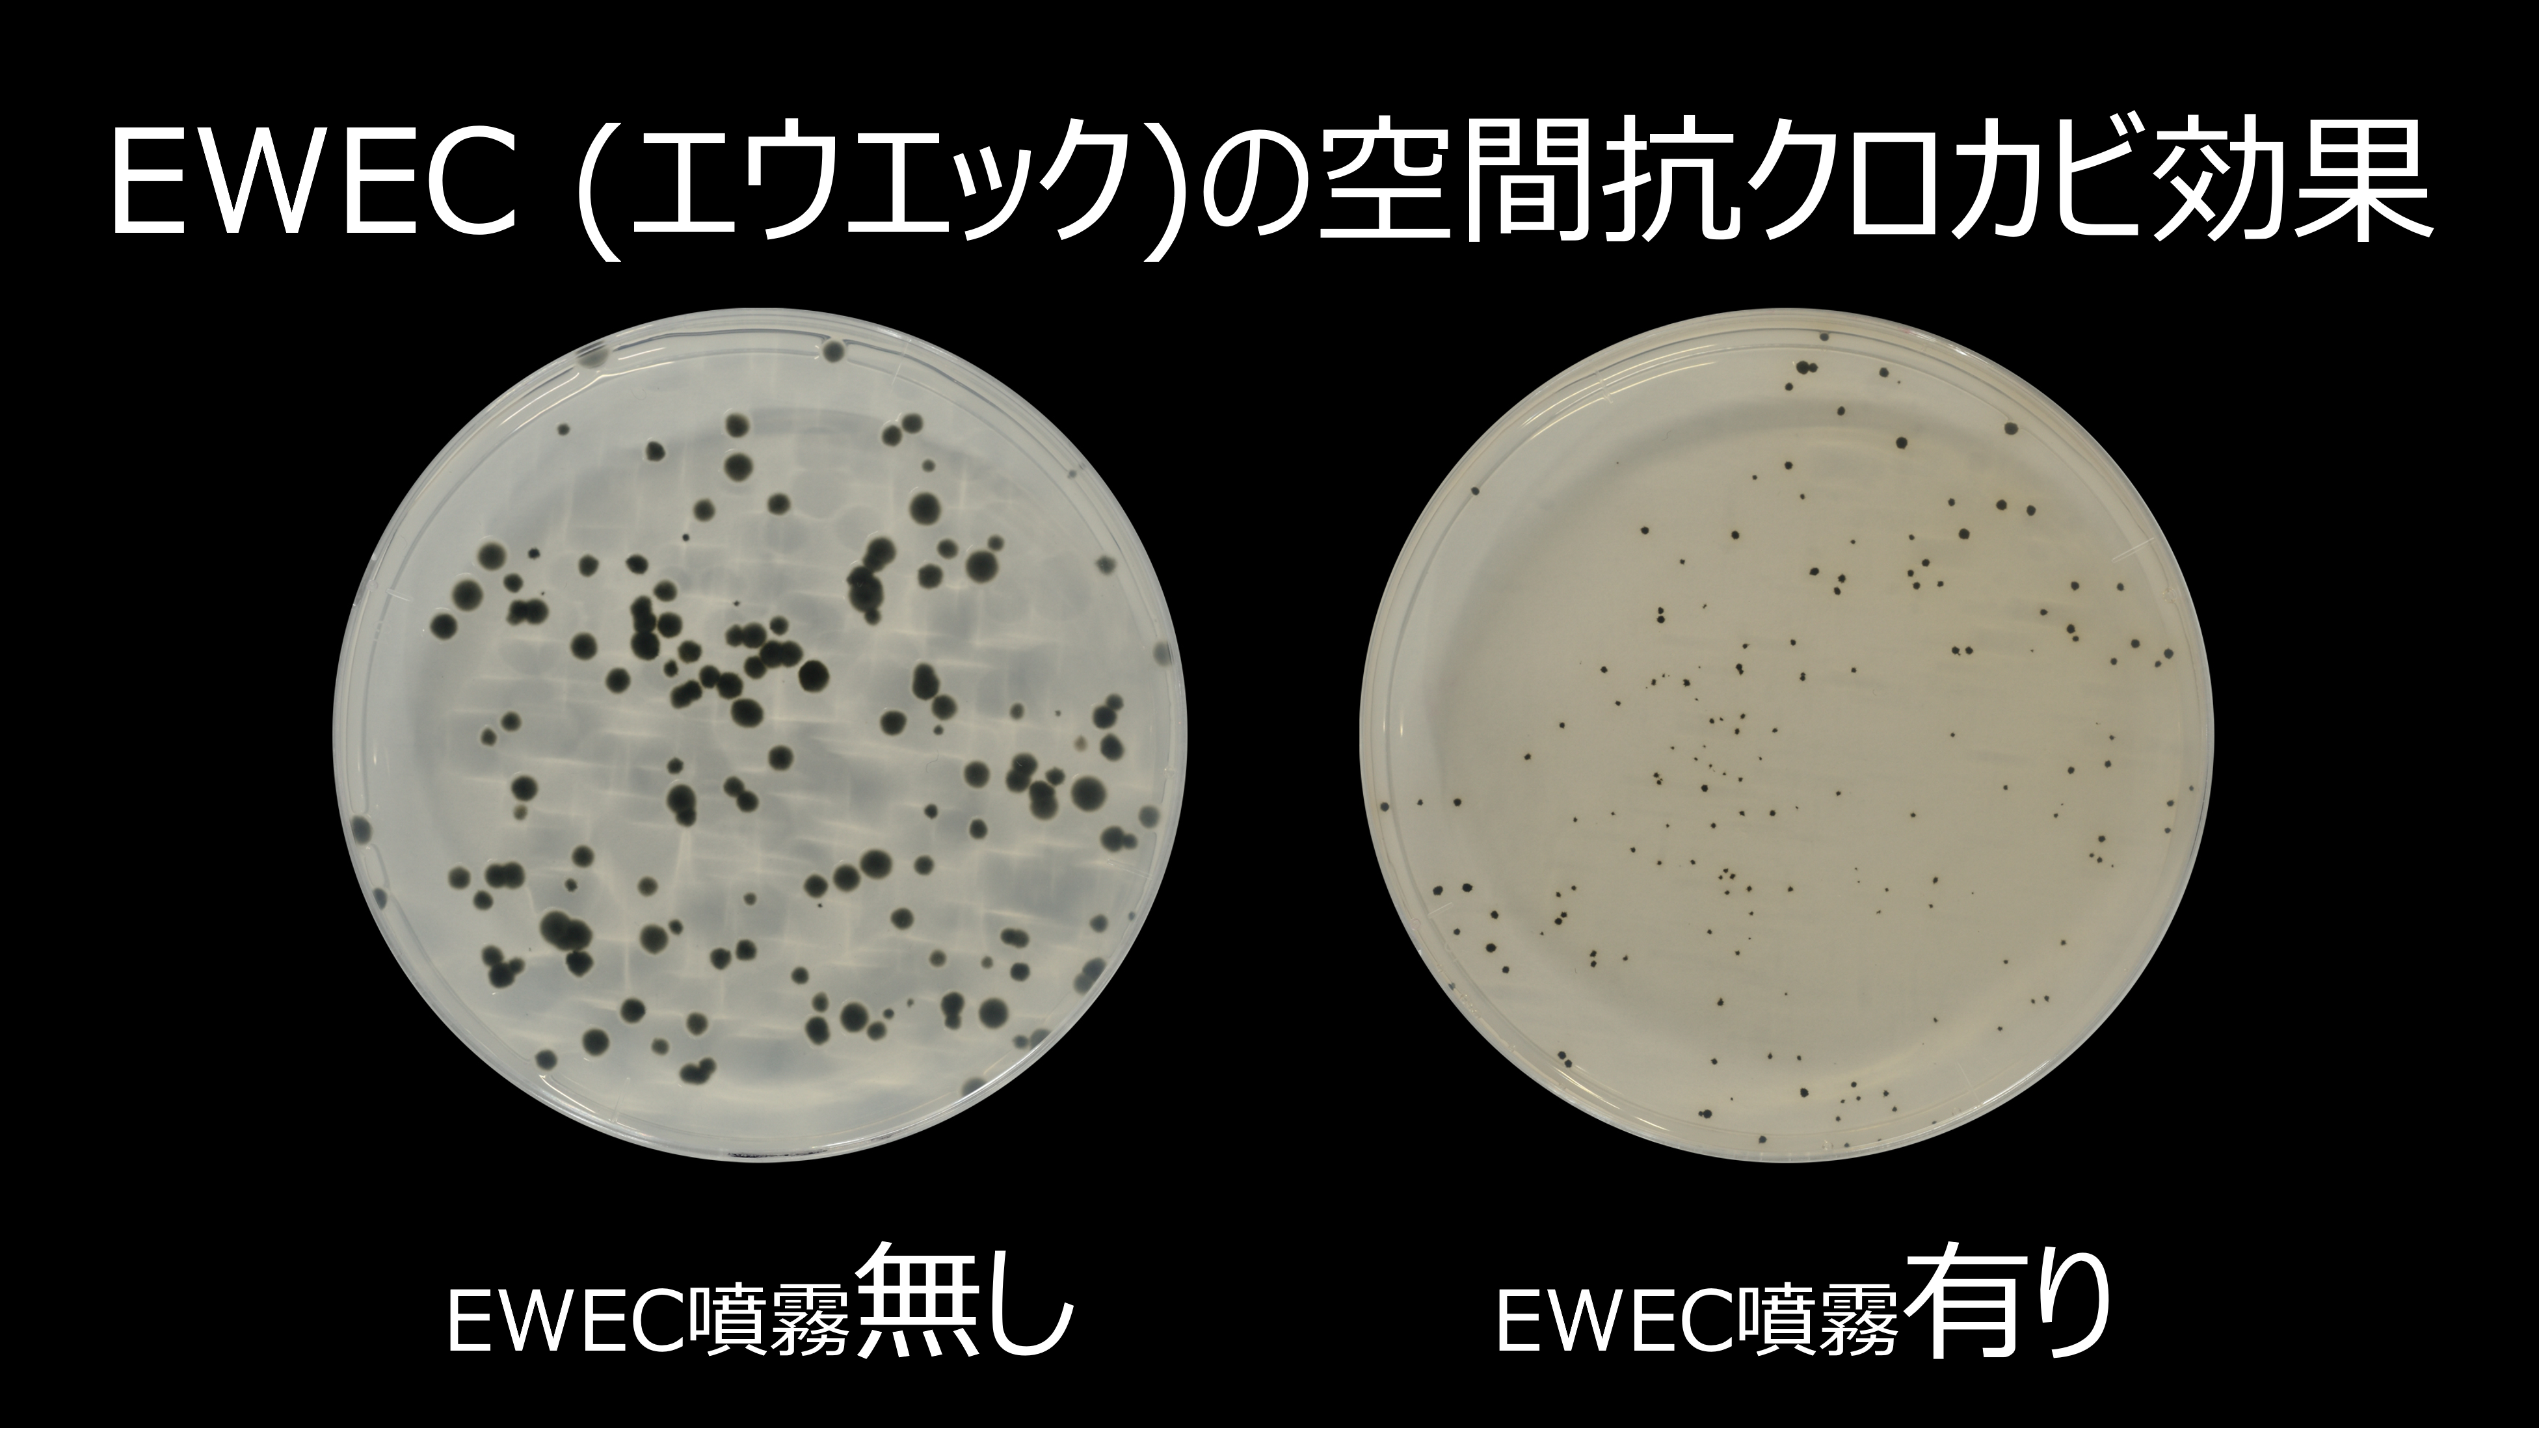

ヒバの防カビスプレー EWEC (エウエック) 150cc
「空間を、ヒバの香りと力で防カビ化する」
詳細はこちらのリンクからもご覧になれます。
https://aurarika.com/lp-ewec/
「EWEC」は、避難所での畳のカビ発生事例をきっかけに開発された、環境表面の衛生管理をサポートする抗カビスプレー です。
畳や段ボールベッドなど、被災地に搬入された後でも簡単に塗工できるよう設計されています。
災害時の衛生環境づくりから、一般家庭の日常的なケアまで幅広く活用できるソリューションです。
塩素系薬剤とは異なり、青森ヒバ由来成分を主体とした処方のため、自然素材を活かした環境づくりを求める場面でも使用しやすい 仕様となっています。
※人体への効果を示すものではありません。
【使用対象】
湿度が高く、ホコリ・皮脂・食べカス・布や木材などの栄養源が存在し、カビが発生しやすい環境のケアにご使用いただけます。
・避難所:段ボールベッド、畳、間仕切り
・一般家庭:寝具、布団、押入れ、収納スペース
・建物内部:壁・床の隅、窓・サッシまわり
・水回り:トイレ、浴室、洗面所 など
事前にスプレーしておくことで、対象環境の衛生管理をサポートします。
【特徴】
● 空間中のカビに対する抑制効果(第三者試験で確認)
第三者機関による試験において、塗布箇所周辺の空間におけるカビ発生の抑制効果が確認されています。
環境の衛生維持を目的とした製品として、「EWEC」の大きな特長です。
※人体への効果を示すものではありません。
● ヒバの香りによる快適性
青森ヒバ特有の香りが広がり、空間を心地よく整えます。
(香りによるリラックス感は個人差があります)
● 自然素材を主体とした処方
青森ヒバ抽出成分・柑橘系有機酸など、自然由来成分を中心に構成しています。
【主成分(素材・原料)】
青森ヒバの抽出成分、柑橘系有機酸、精製水、アルコール
【容量(内容量)】
使いやすい150ccスプレーボトル
【製造国】
製造国は日本で、厳格な品質管理の下で作られています。
【使用方法】
対象物から20〜30cm離して、適量をスプレーしてください。
布製品などには目立たない部分で試してからご使用ください。
空間に使用する場合は、部屋の四隅に1〜2回スプレーしてください。
¥1,650
【保管条件】
・火気の近くを避けて保管してください。
・直射日光・高温多湿を避けて保管してください。
・乳児・お子さま・ペットの手の届かない場所で保管してください。
【使用上の注意】
・本来の用途以外には使用しないでください。
・ 飲料ではありません。誤飲した場合はすぐに医師の診察を受けてください。
・目に入らないようご注意ください。目に入った場合は、直ちに水でよく洗い流し、異物感や異常が残る場合は専門医にご相談ください。
・ 肌に直接使用しないでください。
・猫や小動物のいる環境では使用しないで下さい。
・ 火気には十分ご注意ください。
・換気の良い場所でご使用下さい。
・天然成分を含むため、沈殿や濁りが生じることがありますが、品質には問題ございません。